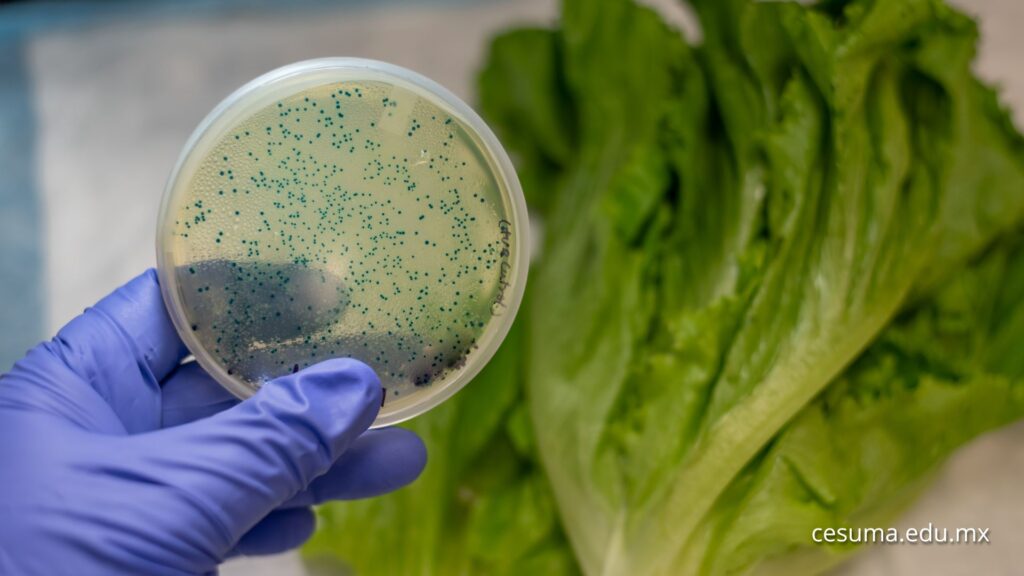

La industria alimentaria enfrenta desafíos significativos en la actualidad, desde el cumplimiento de rigurosas normativas hasta la creciente demanda de los consumidores por productos seguros y de alta calidad. En este escenario, el papel del consultor de calidad y seguridad alimentaria emerge como fundamental para guiar a las empresas hacia prácticas que aseguren la integridad y excelencia en sus productos. Aquí exploramos en detalle el perfil de este profesional clave.
Educación y formación especializada
Un consultor de calidad y seguridad alimentaria destaca por su sólida formación académica en disciplinas cruciales como ciencia de los alimentos o ingeniería alimentaria. Esta base educativa proporciona el conocimiento técnico necesario para comprender a fondo los procesos alimentarios, desde la producción hasta la distribución. Además, muchos de estos profesionales buscan la excelencia académica, obteniendo títulos avanzados y certificaciones específicas en normativas alimentarias y sistemas de gestión de calidad reconocidos a nivel internacional. Esta especialización garantiza que estén al tanto de las últimas tendencias y regulaciones en constante evolución.
Experiencia en la industria alimentaria
La experiencia práctica en diferentes sectores de la industria alimentaria es un componente esencial del perfil de un consultor de calidad y seguridad alimentaria. Haber trabajado en diversas etapas de la cadena alimentaria, desde la producción inicial hasta la distribución final, les otorga una comprensión integral de los procesos y desafíos específicos en cada fase. Esta experiencia de primera mano les permite abordar problemas desde una perspectiva práctica y adaptar soluciones según las complejidades del entorno empresarial.
Conocimiento profundo de normativas y estándares
El consultor de calidad y seguridad alimentaria no solo es consciente de las normativas locales e internacionales que rigen la industria, sino que se erige como un experto en estas. Desde las estrictas regulaciones de la FDA en Estados Unidos hasta las normas globales del Sistema de Gestión de Inocuidad Alimentaria (ISO 22000), su conocimiento abarca un espectro amplio. Este entendimiento profundo les permite asesorar a las empresas sobre cómo cumplir con estos estándares y, a su vez, implementar sistemas que garanticen la seguridad y calidad alimentaria.
Habilidades analíticas y resolutivas
La capacidad analítica y resolutiva de un consultor se traduce en la habilidad para analizar datos complejos y proponer soluciones efectivas. Llevan a cabo auditorías minuciosas para evaluar la conformidad con los estándares establecidos, identificando áreas de mejora y brindando recomendaciones prácticas. Estas habilidades no solo aseguran el cumplimiento normativo, sino que también contribuyen a la mejora continua de los procesos, fortaleciendo la calidad y seguridad alimentaria.

Comunicación efectiva y habilidades de capacitación
La comunicación clara es una competencia clave para los consultores de calidad y seguridad alimentaria. Deben ser capaces de transmitir recomendaciones de manera efectiva y capacitar al personal en las mejores prácticas. La elaboración de informes detallados, presentaciones efectivas y la conducción de sesiones de formación son parte integral de su trabajo. Estas habilidades aseguran que todos los miembros del equipo comprendan y apliquen correctamente los estándares y protocolos establecidos.
Enfoque proactivo y adaptabilidad
La industria alimentaria es dinámica y está sujeta a cambios constantes. Un consultor exitoso se destaca por su enfoque proactivo y su capacidad para adaptarse rápidamente a los cambios en el entorno normativo y tecnológico. Están siempre alerta ante nuevas regulaciones y desafíos emergentes, garantizando que las prácticas de la empresa estén al día y en línea con los estándares actuales.
Compromiso ético y responsabilidad social
El compromiso ético y la responsabilidad social son valores fundamentales en el perfil del consultor de calidad y seguridad alimentaria. Actúan con integridad, asegurando que las empresas no solo cumplan con las normativas, sino que también adopten prácticas sostenibles y éticas en la producción de alimentos. Este enfoque ético contribuye a la construcción de una reputación sólida y a la confianza del consumidor.
Certificaciones y actualización continua
La búsqueda constante de la excelencia se refleja en la obtención de certificaciones reconocidas en calidad y seguridad alimentaria. Desde la Certificación en HACCP (Análisis de Peligros y Puntos Críticos de Control) hasta auditorías específicas de terceros, estas certificaciones demuestran el compromiso del consultor con la calidad y la mejora continua. Estar actualizado con las últimas certificaciones y conocimientos es esencial para ofrecer asesoramiento y servicios que estén alineados con las mejores prácticas y estándares de la industria.
En resumen, el consultor de calidad y seguridad alimentaria desempeña un papel crucial en la garantía de productos alimentarios seguros y de alta calidad. Su combinación de educación especializada, experiencia en la industria y habilidades analíticas lo convierte en un activo invaluable para las empresas que buscan la excelencia en un mercado cada vez más exigente.